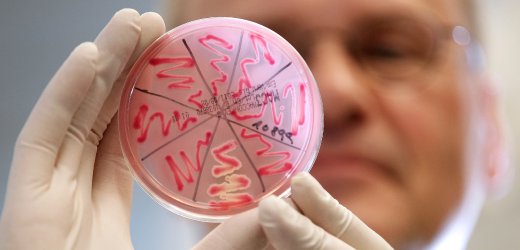

Escherichia coli: cos’è e come avviene il contagio

I rischi per la nostra salute che derivano dall’Escherichia coli
La morte della maestra di Roma è dovuta alla meningite, ma non a una forma trasmissibile. Questo perché non c’è un solo colpevole per la meningite batterica. Spesso si teme il meningiococco, che si può trasmettere da persona e persona, oltre allo Streptococcus pneumoniae e al Haemophilus influenzae. Ma in questo caso, a colpire è stato un batterio che normalmente è presente nell’intestino: l’Escherichia coli. È raro che provochi un’infezione fatale alle meningi degli adulti.
La maggior parte dei ceppi di Escherichia coli sono innocui, ma ne esistono alcuni che mettono a rischio la salute umana: causano disturbi di diversa gravità con crampi addominali, vomito e diarrea con sangue.
L’infezione da Escherichia coli, spiegano dall’ospedale milanese Humanitas, “può provenire da acqua o cibo contaminati – soprattutto da alimenti come frutta e verdura, che vengono spesso consumati crudi, ma anche da latte non pastorizzato e carne non cotta – può risultare molto pericolosa soprattutto per i bambini piccoli e gli anziani, che possono sviluppare una forma di insufficienza renale pericolosa per la vita chiamata sindrome emolitico uremica”. Fortunatamente, però, “l’Escherichia coli è sensibile al calore: la cottura dei cibi permette quindi di neutralizzarlo”. Nessun farmaco, spiegano dall’Humanitas, è in grado di proteggere dall’infezione da Escherichia coli.
I principali sintomi dell’infezione:
- diarrea anche con sangue
- crampi addominali
- nausea
- vomito
Ecco i comportamenti da adottare per non incorrere nell’infezione:
- evitare cibi ‘a rischio’ come carne non cotta a sufficienza e latte non pastorizzato
- lavare accuratamente gli alimenti crudi
- pulire gli utensili da cucina con acqua calda e sapone prima e dopo il contatto con prodotti e carne cruda
- utilizzare contenitori separati per ogni alimento
- lavarsi bene le mani prima di cucinare, dopo essere stati in bagno, dopo aver cambiato pannolini e dopo aver toccato animali
benessere, escherichia coli, Infezioni, meningite, salute

I commenti sono chiusi.